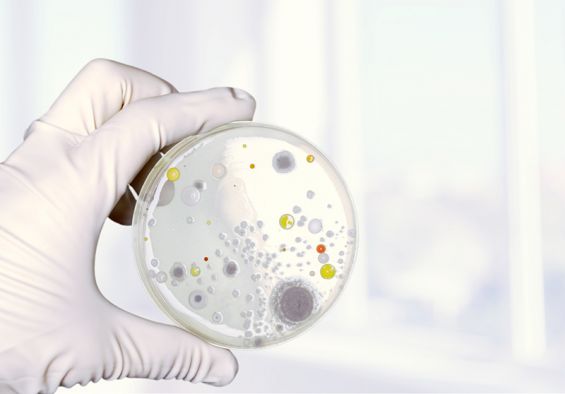

Es gibt tausend Krankheiten, aber nur eine Gesundheit.
Das Sachverständigenbüro für Innenraumanalytik und Umweltmedizin
Ein gesundheitsbewusstes Leben und ein gesundes Arbeits- und Wohnumfeld haben in einer Zeit zunehmender Allergieerkrankungen höchste Priorität.
Ich habe mich in meiner Tätigkeit als Baubiologe auf Innenraumbelastungen durch Schimmelpilze, Bakterien und Schadstoffe spezialisiert. Chemische und mikrobiologische Beeinträchtigungen des Innenraumes werden durch entsprechende Messtechnik und einer eingehenden Begutachtung bewertet.
Meine berufliche Praxis hat mir oftmals aufgezeigt, dass die Gesundheit eines Menschen durch Innenraumschadstoffe erheblichen Belastungen unterliegen kann, und dass es sich oftmals lohnt und auszahlt - sei es aus prophylaktischen oder gesundheitsrelevanten Gründen - für ein gesundes Wohnumfeld zu sorgen.

Unbelastet leben
Ein gesundheitsbewusstes Leben und ein gesundes Arbeits- und Wohnumfeld haben in einer Zeit zunehmender Allergieerkrankungen höchste Priorität.

Allergien, Kopfschmerzen und Unwohlsein
Durch moderne Technik, geschultes Personal und jahrelange Erfahrung kommen wir dem Feind in Ihrer Wohnung/ in Ihrem Haus sehr schnell auf die Spur!
Im Zuge einer Erstanamnese des Gebäudes bzw. der Wohnung oder des Büros führen wir Untersuchungen, wie Feuchtigkeitsmessungen an Bauteilen, Temperaturmessungen an Bauteilen durch. Ebenfalls wird das Raumklima bestimmt.
Wir führen Luftkeimsammlungen, Partikelsammlungen sowie Schadstoffmessungen durch und entnehmen ggf. Materialproben zur Untersuchung im Labor.

Endlich Allergenfrei
Nach Erkennen und erfolgreichem Beheben der Gefahrenquelle wird empfohlen, eine erneute Untersuchung durchzuführen, um sicherzugehen, dass diese wirklich beseitigt wurde.
Die Gesundheit ist unser höchstes Gut und das soll es auch bleiben.

Tätigkeitsfelder
Ortung von Feuchtigkeitsschäden, inklusive Ursachenklärung
Das Team der BMS, bestehend aus Sachverständigen, Trocknungs- und Sanierungsfirmen, ortet, begutachtet und bewertet für Sie Feuchtigkeitsschäden.
Raumluftuntersuchung
Zerstörungsfreie Untersuchungen werden im Zuge von Raumluftuntersuchungen zur Einschätzung möglicher, allergener Belastungen der Raumluft durchgeführt.
Das dient der Umsetzung zielorientierter, tiefergehender Planung zur weiteren Vorgehensweise.
Gutachtenerstellung
Die im Zuge der Bausachverständigentätigkeit (Begutachtung) gewonnenen Erkenntnisse werden in einem schriftlichen Gutachten ausgearbeitet.
STANDORTE / FILIALEN
BMS Düsseldorf
Im Lohauser Feld 63
40474 Düsseldorf
0211-200 79 79 0
WIE GEHEN WIR VOR
Kontaktaufnahme
Zu Beginn einer jeden Beauftragung steht die telefonische Aufnahme der Kontaktdaten meiner Kunden, das Darlegen der jeweilig aufgetretenen Problematik im Innenraum bzw. das Darlegen gesundheitlicher Probleme, zumeist nach der Konsultation eines Umweltmediziners.
Hier kommen
- augenscheinlich erkennbare Schimmelpilzbildungen im Innenraum,
- geruchliche Beeinträchtigungen im Innenraum sowie
- allergische Erkrankungen der Bewohner
in Betracht.
Im Zuge einer anschließend vereinbarten Erstanamnese des Gebäudes bzw. der Wohnung oder des Büros, führe ich erste Untersuchungen, wie Feuchtigkeitsmessungen an Bauteilen / der Raumluft, Temperaturmessungen an Bauteilen / der Raumluft durch. Erläuterungen zum Gesundheitszustand der Bewohner bzw. zu Vorschäden (Feuchtigkeitsschäden) in der Wohnung werden während unserer Erstanamnese ebenso eingehend beleuchtet, wie bautechnische Daten zum Baujahr des Hauses, usw. Das weitere Procedere wird in Absprache mit meinen Kunden individuell und adäquat abgestimmt- hiernach richten sich ferner die während des Termins zu veranschlagenden Kosten für die weiteren, notwendigen Untersuchungen.
Weitere Untersuchungen können
- Luftkeimsammlungen / Partikelsammlungen,
- Schadstoffmessungen, Materialbeprobungen
sein.
Über die Untersuchungsergebnisse wird stets ein schriftlicher Untersuchungsbericht angefertigt, welcher auch Sanierungsempfehlungen aufzeigen kann.
Mir stehen durch meine mehrjährige Praxis als Projekt- und Sanierungsbegleiter diverser Schimmelpilzsanierungsmaßnahmen, sowie durch meine Tätigkeit als Sachverständiger für Baubiologie, kompetente Sanierungsfirmen sowie Umweltmediziner zur Verfügung, die ich gerne an meine Kunden weiterempfehle.
Im Verlaufe einer Schimmelpilzsanierungsmaßnahme werden u. a. entsprechende Reinigungsmaßnahmen (Grob- und Feinreinigung) erforderlich, welche mit größter Sorgfalt in Anlehnung an den Schimmelpilzsanierungsleitfaden 2005 des Umweltbundesamtes bzw. des Landesgesundheitsamtes BaWü auszuführen sind. Die BMS hat sich im Zuge der Projektleitungen mit einem dafür etablierten Team auf diesen wichtigen Part der Reinigung spezialisiert und bietet diese Leistungen auch außerhalb von Sanierungsbegleitungen und Projektleitungen an. Zur Verfügung stehen modernste Industriestaubsauger, welche auch für den Bereich der Asbestsanierung zugelassen sind.
Beprobung
Das weitere Procedere wird in Absprache mit meinen Kunden individuell und adäquat abgestimmt - hiernach richten sich ferner die während des Termins zu veranschlagenden Kosten für die weiteren, notwendigen Untersuchungen.
Weitere Untersuchungen können
- Luftkeimsammlungen,
- Schadstoffmessungen,
- Materialbeprobungen
sein.
Begleitung
Im Zuge notwendiger Sanierungsmaßnahmen, die z.B. den Rückbau von kontaminierten Flächen (Schichtenaufbau Boden, Wandputzflächen, etc.) erfordern, begleiten wir unsere Kunden in Anlehnung an die einschlägigen Richtlinien.
Die Sanierungsbegleitung beinhaltet die Vorplanung einer Maßnahme mit der einzuschaltenden Sanierungsfirma sowie die Koordination derselben im Auftrag unserer Kunden.
Über den Erfolg einer solchen Maßnahme wird ebenfalls ein schriftlicher Bericht verfasst.

Marcel Santner
Ich heiße Marcel Santner, bin 1975 geboren und seit 2000 im Auftrag meiner Kunden als Baubiologe unterwegs. Im Anschluss an meine Ausbildung zum Baubiologen beim Institut für Baubiologie in Rosenheim (IBR) habe ich bis heute zahlreiche Fortbildungsseminare und Messtechnikseminare besucht.
In meinem nun 19. Berufsjahr blicke ich auf interessante Beauftragungen und Projektbegleitungen zurück, die mir gezeigt haben, dass es sich stets lohnt, mit Sachverstand und Hingabe an die Dinge heranzugehen, denn die Gesundheit und ein gesundes Wohnumfeld sind unser höchstes Gut.